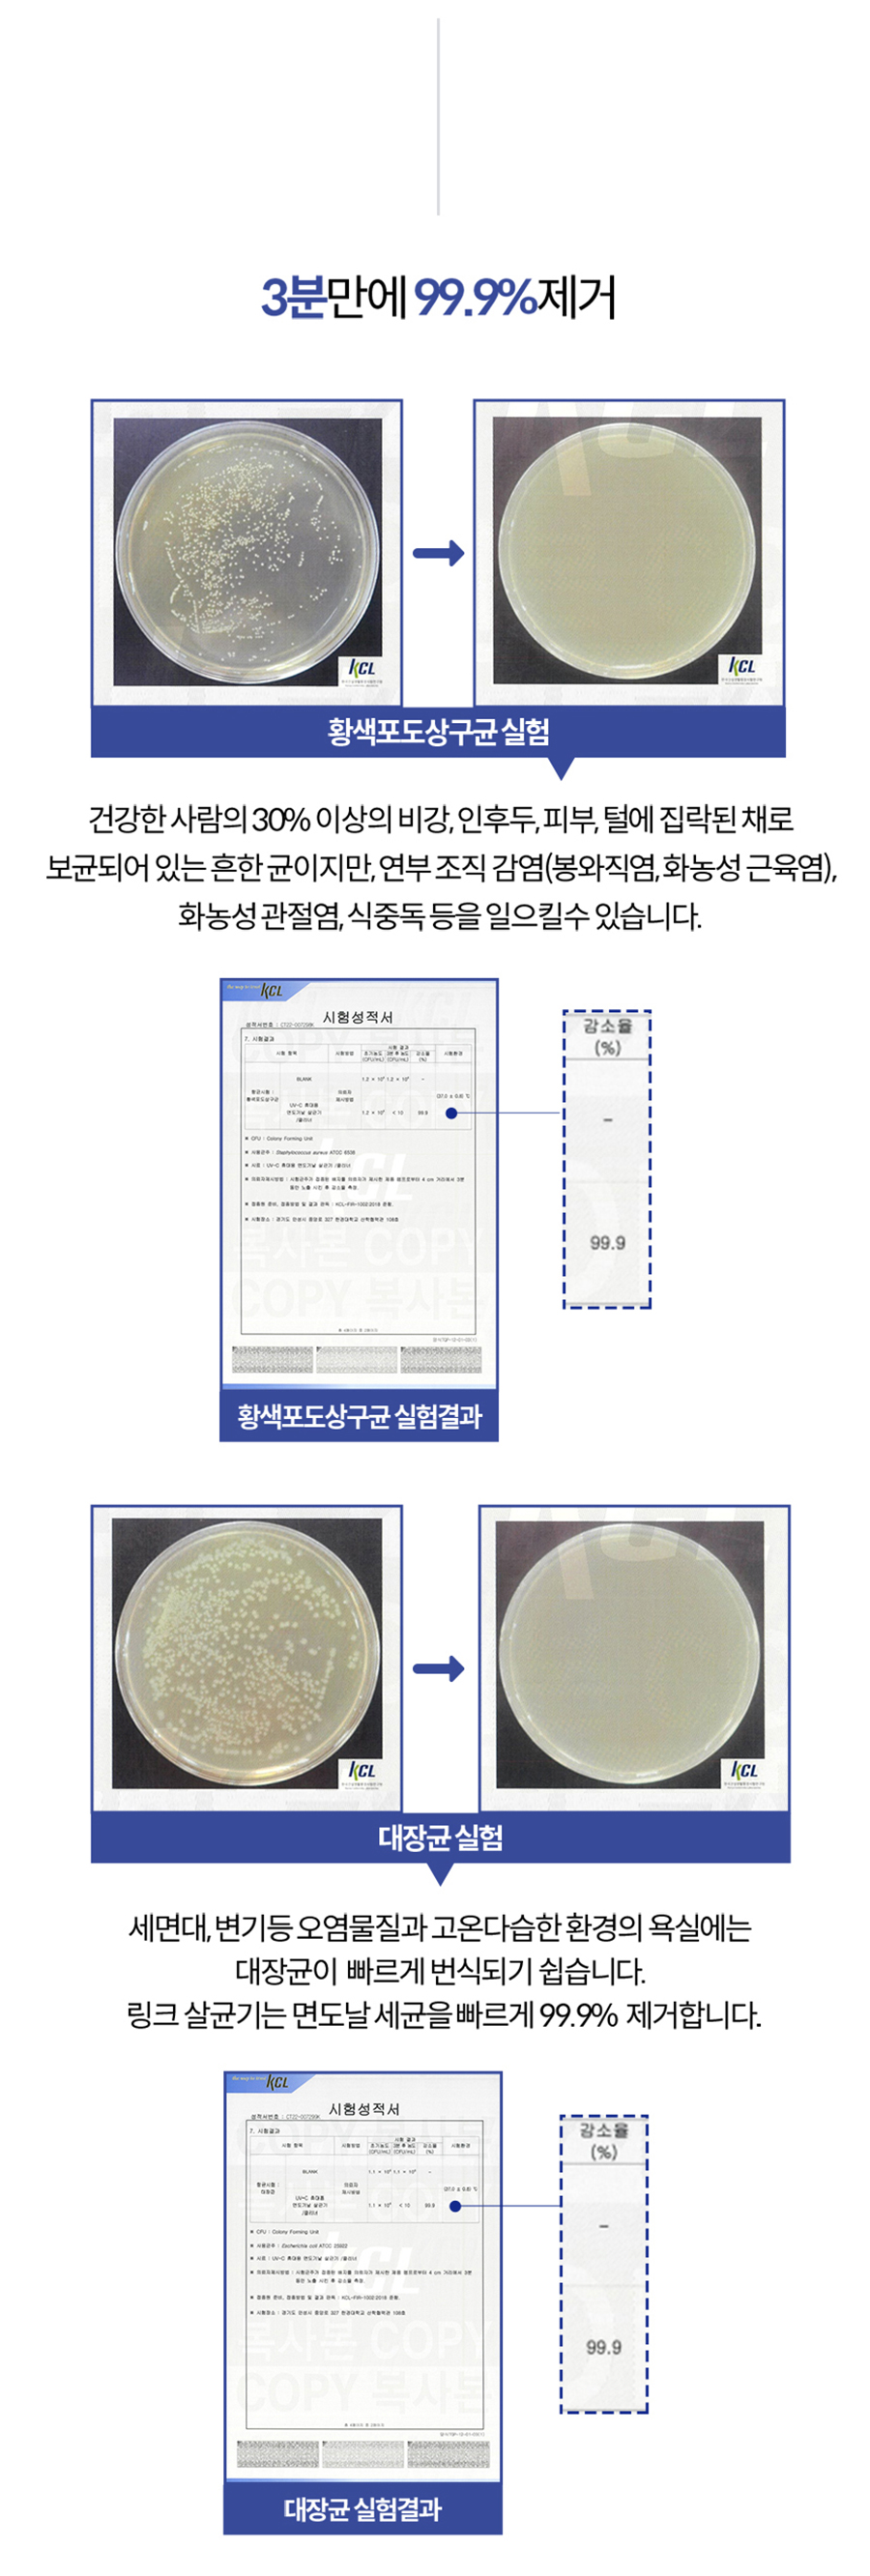
b11-12796-11.jpg

- 가나다라순 상품찾기
-
가
가정/생활/티슈/식품구급/응급용품구급함기타전기용품게임기독교용품거즈/붕대/솜류기타건강관리용품궁중팬/튀김팬공기대접세트기타정수기주변기기골프용품골프공공구가죽밴드시계기능성물티슈기타교구기타이유식용품기타작동완구공/소프트볼거실가구계절베개계절방석기타가구부속품구강청정기구강세정기공유기꽃/케이크배달꽃배달각티슈공구세트기타측정기공구함가습기기타렌즈용품가슴줄가면/머리띠과도/식도거치대가드간판기능화기름종이기타유모차용품기능성방석가구부속품공구곰팡이제거제그릇/용기류기타보관용기깔때기공기검사증/등록증케이스가방기타안마용품구명조끼금은패골프 트로피구둣주걱귀달이모자기타미술놀이기타캠핑용품기타요가용품가리비 상패고급트로피기타신발용품기타스포츠완구감각발달완구기타침구단품공기청정기기타청소용품강아지 배변용품건강슬리퍼곰솥/들통기타잡화고급라이타구두헤라/구두솔/슬리퍼걸레기타주방가전기타헬스소품기타레져용품권투기타소형가전꽃/원예계절가전교구기타잡화귀마개기타인쇄물건강식품교통카드계산기가구/인테리어건강용품기타취사용품고가볼펜(1000원이상)기타건강측정용품고급볼펜(만원이상)공구고무장갑기타주방잡화기타상패건강관리용품구강위생용품구급함기타
- 나
- 다
- 라
-
마
맞춤 라벨 생수목욕가운모기채/파리채마우스패드메모지/메모함머그컵/유리컵믹서기/블렌더모자마사지건무릎보호대매달/뱃지메뉴판머플러마사지도구물티슈모기밴드/퇴치용품모자면/극세사카페트멀티미디어장비모니터받침대미디어보관함모기향미술도구수납용품미용/목욕매트마스크액세서리메모판/미니보드면기머그무선포트미용세트(손톱깎이)모자물놀이용품메탈밴드시계미술놀이무릎담요멀티탭모형카메라목걸이볼펜/핸드폰줄펜마우스명찰밀폐용기미용잡화모자모서리보호대목쿠션/아이필로우먼지떨이/먼지제거기미용가위명함관련용품미용/잡화/시계/거울머니클립밑밥통/살림통명함면봉물조리개무선/RC물통/쉐이크명함지갑물병마스크문갑패매트/안전용품밀대/패드미니달력/스케쥴러메모클립/홀더무선충전거치대만년필마스크보관케이스/위생주변용품모기장매트/돗자리모니터주변기기메모패드목쿠션무선마이크문구세트믹싱볼만보기문풍지목욕용품명함꽂이매직명패물리치료/저주파용품목공공구
-
바
빨래바구니빗자루/쓰레받기부직포정리함바지걸이보드게임반려동물용품브러시/빗배변봉투/집게보행보조용품발지압/발매트비눗갑/홀더/받침변기솔배수구캡빨래바구니보틀/텀블러류보틀(플라스틱)빵칼비누방수팩보관함/케이스부츠바디케어바디로션봉제인형비눗방울복근운동기구밴드분리수거함블록발톱/발 관리빨래건조대부착볼펜보조배터리볼배낭비치볼빌지비니브로치바디클렌저비데용베개커버바란스부채병풍비누꽃비상/구난용품발각질제거기보틀/텀블러세트벽시계발목보호대봉투비눗방울베개발매트보수용품블라인드보안경빨래판비닐접착기반짇고리볼펜형USB바인더벽걸이달력보온보냉병발보호대/패드발매트/목욕가운반상기세트벽거울볼펜세트/케이스볼펜뷰티소품붓통/필병벨트보호용품바스/비치타올봉투개봉칼변환 젠더/케이블비치백배드민턴방울털모자배구보풀제거기반지갑보드마카방향제바구니반려동물보드/칠판보온보냉백백팩버너비닐봉투보스턴가방보안용품발건강용품비닐장갑바비큐그릴/화로대
-
사
손잡이PP부채실내탈취제수평기시트형섬유유연제손소독제스탠드선풍기(탁상용/에어써큘레이터)스탠드선반/진열대서바이벌용품소금세숫대야샤워볼서류철/결재판스프링다이어리상커버식기건조대시계손목시계손거울/휴대용거울스포츠양말스포츠장갑세차장갑살균기스포츠헤어밴드손난로신발용품신발깔창실내화스트랩샌들시계보관함선크림샴푸손소독용스케치북세트손잡이신발건조기스키/보드방한용품샌드백생활편의신발/신발장탈취제세탁세제씨앗/모종식품선물세트솔소품정리함소화기선물박스사무/휴대폰/컴퓨터/USB신분증/사원증/홀더/줄/케이스스텐컵손톱깎이/거울숄더백세정제/항균티슈수영모스티커슈즈커버선글라스/안경테수면양말시계소품스킨케어스킨/토너선스틱생활가전세탁/건조기손목받침대스포츠액세서리스포츠선글라스생활/세제선물세트신발정리대소화기샤워/목욕용품세탁망수첩시스템다이어리수저세트세차타월손가방/파우치실내/실외등수경슬리퍼슬리퍼스포츠양말선케어세안도구손소독기/손세정기스포츠타올/극세사타올생활용품섬유탈취스프레이세탁보조제서바이벌샤프수첩다이어리수정테이프/연필깎이/호치케스스포츠물병쌕(허리쌕)손목보호대사파리모자스타킹샌들샌들색연필서재/사무용가구살균소독제생활가전소품걸이샤워기/수전용품실리콘세차물통선캡스포츠완구솜류스키/보드생활잡화서류가방쇼핑백색조메이크업세정티슈생활선물세트선반/진열대스마트링/스마트톡사무용잡화스트랩/줄상패/행사용품스탠드셀카봉/삼각대/렌즈사무용문구스탠드시계스포츠가방싯업벤치스피커/이어셋/음향/헤드셋세트제품(머니클립/명함지갑)수영용품성냥/재떨이스냅백수납가구스탠드라이트소켓/시거잭수동우산스틱수저함/수저집신생아의류샤워타올소방/안전신발관리도구시장가방/부직포시계수집품세차용품손난로/핫팩싸인펜실습교구/교재스카프소독/살균용품수예수세미식탁매트손수건스포츠/레저사무용가위수저통썬캡생리대스탬프/도장스포츠마스크사무용칼스포츠넥워머선글라스클립수납용품수작업공구실버용품상패식기스포츠토시상장케이스세탁용품설거지용품섬유유연제세탁용품세제/세정제
-
아
일반물티슈음식물쓰레기통액자욕실용품선물세트안대아크릴물감울타리안전표시/신호압축분무기안전장갑욕실잡화이동접이식인주함일반형USB자야광용품외장HDD아이스트레이와인액세서리세트유리컵일반밥솥온풍기열쇠고리여권지갑의류용품워셔액야외의자여행용세트오리발우승컵트로피인쇄물안경소품야구모자일반캡일반캡압박보정스타킹여성양말여성장갑에센스유모차용품유모차정리망/정리함의자의자발받침대이불솜일반이불솜인테리어조명우산꽂이이불베개세트웹캠웨이트용품아이스머플러/스카프요가링/필라테스링일반타올일회용 건전지일반섬유유연제압축팩안전모욕창방지용품욕실화욕실용기/홀데욕실청소도구의료용압박스타킹원목사무용품양장다이어리양수냄비안마기오카리나업소용품안경줄아쿠아슈즈유니폼화여성양말안전잠금장치언어/학습완구인테리어의자액세서리악력기욕실용품외출용품이동장/이동가방원예공구욕실세트야채칼세트에어프라이어열쇠고리세트안전벨트용품여행소품케이스위생항균키트우산오프너암워머/토시인형워터볼웨이트기구요가/필라테스온도계/습도계입마개안전용품여행용세트욕실청소용품양념통원목탁상시계우산위생 마스크여행용품원목/꼭지퍼즐왕골자리일반방석욕실시계양말아동우산위생/건강인쇄마스크운동용품웨이트용품유아동퍼즐일반쿠션아로마/캔들용품운동밴드옷걸이연필앞치마우의이쑤시개와인오프너일반지갑/여성지갑여행용가방양산야전침대요가매트에칭패이미용가전여행티슈여행용세면용품유리닦이용품우산세트아이스박스/보냉백어깨보호대원목패인쇄물/업소용품여성신발이유식용품인테리어소품와인잔우산/타올세트이태리양말완구/인형업소용믹서기음료이어폰위생팩/지퍼백인테리어용품유모차음향가전인테리어용품에코백아이젠유아동잡화에코백세트안마용품악기약통익스테리어용품아동/주니어가구여가/생활편의안전용품오디오와인용품이벤트/파티용품여행용세트일회용식기여성언더웨어/잠옷오일/소모품의료용품일회용빨대유니폼/단체복워터저그욕실용품운반용품
-
자
저주파안마기자세교정용품좌욕기자전자칠판주걱전기찜기전기방석전기장판잠옷/홈웨어정장세트잠금벨트/자물쇠자석스티커주얼리소품종이/입체퍼즐작동완구젖병솔주방장갑조명자전거용품장갑장갑접이식PP부채정리용품점착메모지줄자지퍼백전기요/담요/방석전기요자켓/점퍼/바지줄넘기/스트레칭자연/과학교구주방데코전통공예소품전동칫솔자전거의류/잡화지갑티슈주방용타올.고리타올전통부채제습제저울접착제전선정리용품주방/가전/보틀/텀블러찜기잡화조끼/운동복젤리/우레탄밴드시계좌식의자조화정리함족욕/족탕기자개형 USB주방잡화주방가위세트전골냄비조리도구세트전기포트/주전자전기매트/장판전통공예품지갑/벨트/넥타이핀자동우산지압기장갑주얼리장식인형자전거전사타올전화기록부/앨범주방용품주방기구세트집게전기그릴자개거울전단지줄넘기저금통주방가전장우산/골프우산종이컵직화냄비정수기장갑자전거/용품주방잡화주전자전기팬잠시주차증접시주방홈세트전기냄비재봉틀재떨이저장장치주방장갑/호일전자레인지/오븐 용기쟁반전통파우치찜질팩/쿨팩자개패장갑주변기기지우개전기밥솥지압기/마사지기쟁반패자외선소독기장지갑장화/안전화주석패저장장치주방세제전기쿠커장갑짤프패저가볼펜(300원미만)제습/방향/탈취조미료중가볼펜(300원~1000원)주방저울주방가구종교조리기구중대형 캐리어절구전기용품주방정리소품잔/컵주방수납용품재활운동용품제과/제빵용품좌욕/좌훈용품전동공구
- 차
- 카
- 타
- 파
-
하
호신용품화장지케이스핸디스틱청소기화분허브차화구통/박스혈압계하모니카헤어핀헤어소품헤어브러시학습교구화장대학습보조기휴대폰케이블헬스혀클리너확대경항아리후라이팬세트하이라이트핸드폰줄화장품핫팩헤어끈현관조명헬스소품휴대폰/컴퓨터/음향히터핸드크림호각/호루라기헤어액세서리소품핸드케어학습기기헤어기기휴대폰주변용품(스마트워치)헤어밴드헤어케어화장품케이스휴대용해충퇴치기헬스장갑훌라후프형광펜휴대폰충전기/케이블화장용품학원가방/보조가방헤어브러시휴대폰액세서리히터/난로휴대폰거치대화일후라이팬허리보호대헤어액세서리휴지통현수막/배너홈데코헌팅캡핸드블렌더후레쉬화장품/미용휴대용선풍기핸드카트행주핫플레이트화방용품해충퇴치용품행사해먹화장지
- A-Z
- 숫자
- 용도별 추천상품
- 최근 본 상품
-
없음

- 상품정보
- 상품평
- 상품문의
- 배송/교환/반품안내
| 규격 | 65mm X 195mm X 45mm | 색상 | 네이비 |
|---|---|---|---|
| 인쇄 | 실크인쇄 | 재질 | ABS, TPE, 실리콘 |
| 케이스 및 포장 | 종이케이스 | 제작기간 | 시안 확정 후 4~7일 |
| 원산지 | 한국 | 1박스당 | |
| 기타사항 | |||

전자상거래 등에서의 상품정보제공고시
| 품명 | 상품페이지 참고 |
|---|---|
| 모델명 | 상품페이지 참고 |
| 법에 의한 인증·허가 등을 받았음을 확인할 수 있는 경우 그에 대한 사항 | 상품페이지 참고 |
| 제조국 또는 원산지 | 상품페이지 참고 |
| 제조자 | 상품페이지 참고 |
| A/S 책임자와 전화번호 또는 소비자상담 관련 전화번호 | 캔디 : 070-5043-0199 |
- 상품정보
- 상품평
- 상품문의
- 배송/교환/반품안내
- 상품정보
- 상품평
- 상품문의
- 배송/교환/반품안내
- 상품정보
- 상품평
- 상품문의
- 배송/교환/반품안내
배송 안내
반품/교환 안내
|
전체메뉴 보기
펼쳐보기
-
캔디 대표자 : 김성룡 전북특별자치도 익산시 인북로 168(남중동)
사업자등록번호 : 402-12-24439 사업자정보확인 통신판매업신고 : 제 2020-전북익산-0669호
고객센터 : 070-5043-0199 FAX : 0505-332-7759 Email : candy0863@naver.com
개인정보보호책임자 : (candy0863@naver.com)캔디의 사전 서면 동의 없이 사이트의 일체의 정보, 콘텐츠 및 UI등을 상업적 목적으로 전재, 전송, 스크래핑 등 무단 사용할 수 없습니다.
Copyright ⓒ 캔디 All rights reserved.
-
에스크로 구매안전서비스
고객님은 안전거래를 위해 현금으로 5만원이상 결제시 구매자가 보호를 받을 수 있는 구매안전서비스(에스크로)를 이용하실 수 있습니다.
보상대상 : 미배송, 반품/환불거부, 쇼핑몰부도







